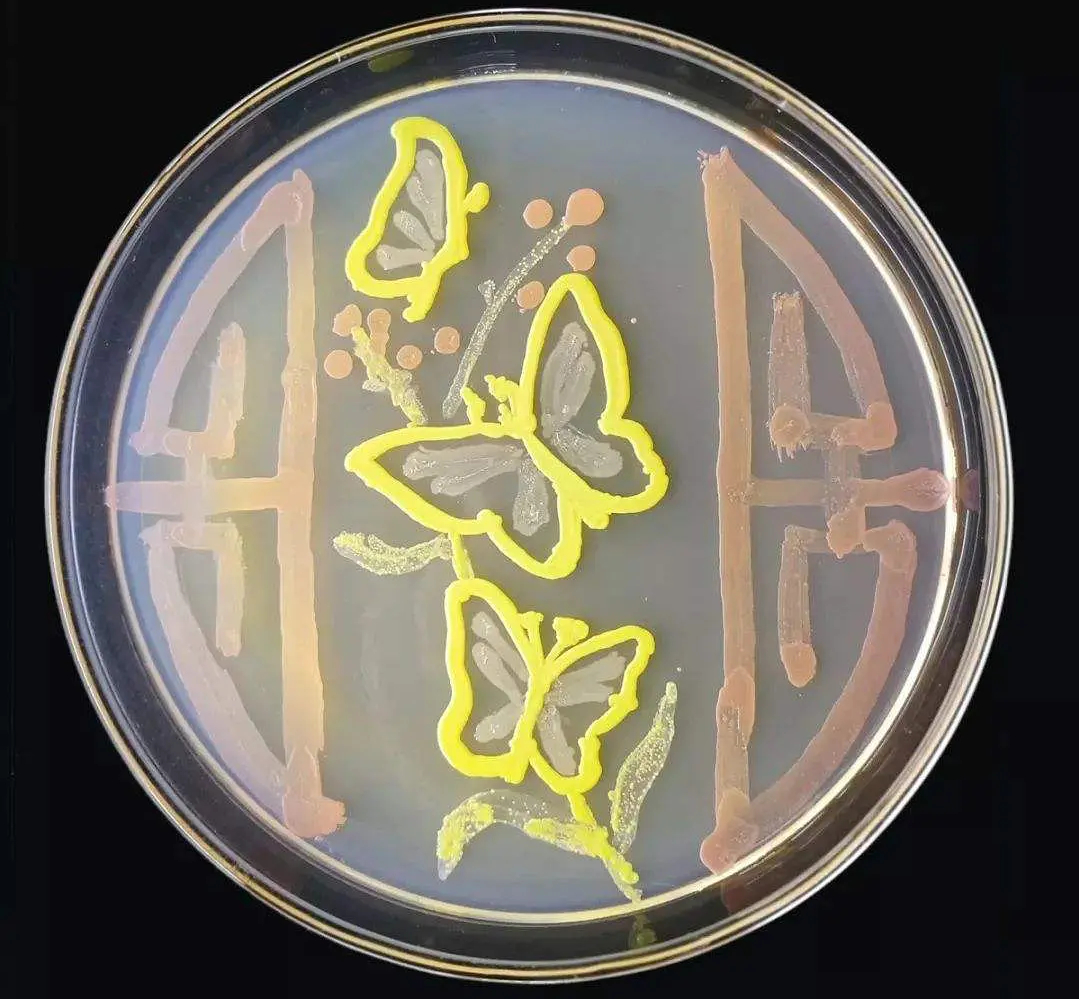
来看看微生物培养皿大赛的作品吧__财经头条

微生物培养皿

皮氏培养皿,垂直画幅,生物科技,微生物学,手
图片尺寸800x1200
越来越多的病毒和细菌细胞的培养皿.微生物
图片尺寸1024x713
青春献礼二十大2022年京津冀高校微生物培养皿大赛暨青春献礼二十大
图片尺寸403x537
大家帮我看看培养皿是什么菌啊 - 食品微生物检测 - 食品论坛
图片尺寸2560x1920
培养皿,微生物,培养
图片尺寸525x350
培养皿中,突起的像花瓣一样的菌落是什么?
图片尺寸936x1664
医院环境微生物及消毒灭菌效果监测 69 哪位老师提供一下空气培养皿
图片尺寸1002x752
做菌落总数时,培养皿底部长出花状,求分析原因 - 食品微生物检测
图片尺寸1080x1440
一次性塑料培养皿55mm接触皿接触碟表面接触性平皿微生物取样皿
图片尺寸3024x3024
13 2011-05-23 平板培养微生物时为什么要把培养皿倒置?
图片尺寸290x300
来看看微生物培养皿大赛的作品吧__财经头条
图片尺寸1079x999
培养皿总是长成片菌 - 食品微生物检测 - 食品论坛 - powered by
图片尺寸1334x1001
培养皿细菌培养
图片尺寸700x489
被科学耽搁的亚历山大:发现青霉菌不被重视,微生物作画流传至今
图片尺寸640x613
细菌培养皿医疗特写显微镜下的细菌背景图片细菌病原感染病菌医疗科技
图片尺寸1280x853
培养皿_细菌_培养_检查_颠倒_亮光_显微镜_微生物学_实验室_图片大全
图片尺寸794x596
默克merck milliflex 溴棕三甲铵琼脂培养皿 mxsmcet48
图片尺寸600x590
微生物细菌培养皿
图片尺寸525x350
于是,就有了学生们以培养皿为画布,以微生物为颜料,在培养皿上创作的
图片尺寸918x705
皮氏培养皿上的蓝奶酪微生物
图片尺寸460x459